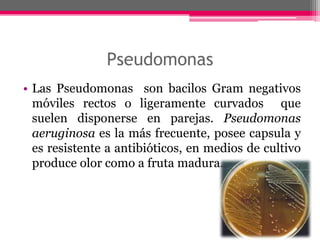
Pseudomonas
• Las Pseudomonas son bacilos Gram negativos
  móviles rectos o ligeramente curvados que
  suelen disponerse en parejas. Pseudomonas
  aeruginosa es la más frecuente, posee capsula y
  es resistente a antibióticos, en medios de cultivo
  produce olor como a fruta madura.

1) El documento describe la flora normal y patógena que se encuentra en diferentes partes del cuerpo humano como la piel, boca, intestinos y aparato respiratorio. 2) Explica los principales géneros bacterianos como Staphylococcus, Streptococcus, Pseudomonas, Candida y Chlamydia que pueden estar presentes de forma normal o causar infecciones. 3) También menciona virus y parásitos patógenos y las enfermedades que pueden producir al colonizar diferentes órganos como la faringitis, neum